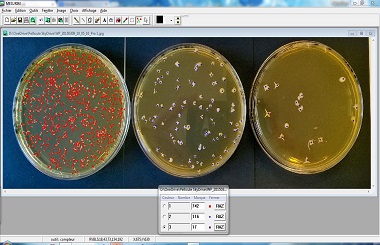

Analyses Agro-alimentaires
Analyses Agro-alimentaires
L'analyse agro-alimentaire est cruciale pour garantir la sécurité, la qualité et la conformité des produits alimentaires. Elle englobe une variété de tests et méthodes visant à évaluer les composants, les contaminants et les propriétés des aliments.
Elles nécessitent des méthodes rigoureuses et conformes aux normes pour assurer la protection de la santé publique et la confiance des consommateurs.

Analyse microbiologique (pathogènes,flore totale.)
L’analyse microbiologique est un domaine essentiel dans la sécurité alimentaire, la santé publique et le contrôle de qualité. Elle permet de détecter et d'identifier les micro-organismes présents dans divers échantillons, notamment les aliments, l'eau et les surfaces.
L'analyse microbiologique est essentielle pour garantir la sécurité et la qualité des aliments et pour protéger la santé publique. Elle nécessite des méthodes rigoureuses et conformes aux normes afin de fournir des résultats fiables et pertinents, contribuant ainsi à la prévention des épidémies et à la promotion d'une alimentation sécuritaire.
Analyse chimique (résidus de pesticides, métaux lourds, additifs)
L'analyse chimique des résidus de pesticides, des métaux lourds et des additifs dans les produits alimentaires est essentielle pour garantir la sécurité alimentaire et la conformité réglementaire.
Elle nécessite des méthodes rigoureuses et le respect des normes pour garantir des résultats fiables et significatifs. Ces analyses jouent un rôle clé dans la prévention des risques alimentaires et le maintien de la confiance des consommateurs.


Analyse nutritionnelle (protéines, lipides, glucides, vitamines)
L'analyse nutritionnelle est essentielle pour évaluer la composition des aliments et déterminer leur contribution à l'alimentation humaine. Cette analyse comprend la quantification des macronutriments (protéines, lipides, glucides) et des micronutriments (vitamines).
L'analyse nutritionnelle est essentielle pour garantir que les aliments répondent aux besoins nutritionnels des consommateurs et respectent les normes de sécurité. Elle nécessite des méthodes rigoureuses et précises pour fournir des données fiables, contribuant ainsi à la promotion de la santé publique et à l'éducation nutritionnelle.
Analyse sensorielle (goût, texture, arôme)
L'analyse sensorielle est une méthode scientifique utilisée pour évaluer les caractéristiques organoleptiques des produits alimentaires, telles que le goût, la texture et l'arôme. Elle joue un rôle crucial dans le développement de nouveaux produits, le contrôle de la qualité et l'amélioration des recettes.
L'analyse sensorielle est un outil essentiel pour l'industrie alimentaire, permettant d'évaluer et d'optimiser les caractéristiques des produits en fonction des attentes des consommateurs. Grâce à des méthodes rigoureuses et à des panels de dégustation, elle contribue à garantir la qualité, la sécurité et la satisfaction des produits alimentaires.


Analyse de contaminants (mycotoxines, allergènes, toxines naturelles)
L’analyse des contaminants, y compris les mycotoxines, les allergènes et les toxines naturelles, est cruciale pour garantir la sécurité alimentaire et protéger la santé des consommateurs.
Elle nécessite des méthodes rigoureuses et le respect des normes pour fournir des résultats fiables et significatifs, contribuant ainsi à la prévention des risques alimentaires et à la promotion de la santé publique.
